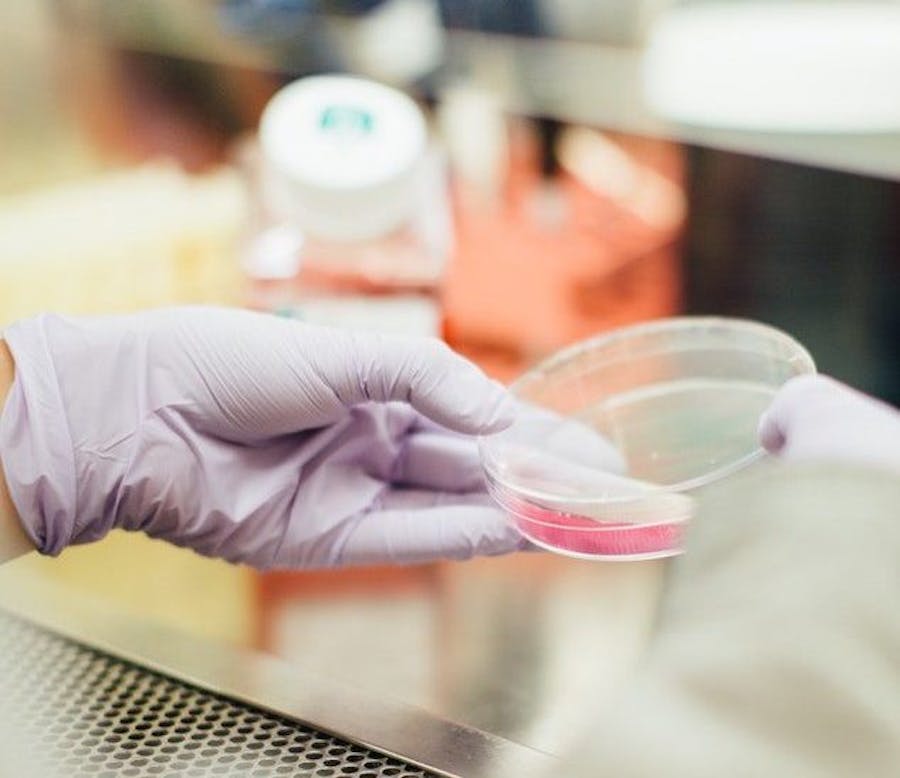
I+D+i, ‘that’s the question’ I+D+i, 'that's the question'

«Desde la fabricación de las primeras herramientas de piedra en el Paleolítico hasta el logro de curar e inmunizar ratones con cáncer de colon, hay un factor común que une estos casi 3 millones de años: la I+D+i». Como en la propia evolución de las especies, en el mundo empresarial es fundamental invertir parte importante de nuestros recursos en I+D+i para ser más competitivos y no perecer en el camino. Es la fórmula que permite a las empresas avanzar hacia el éxito. En este mundo globalizado e hiperconectado, la velocidad a la que evoluciona la tecnología hace que las organizaciones tengan que ser muy ágiles y flexibles en el desarrollo de nuevos o mejorados productos, procesos o servicios. Pero, ¿cuáles son las tendencias tecnológicas a nivel empresarial que más van a mover los pilares de la economía tradicional en el corto plazo? «La Inteligencia Artificial, el Blockchain, la Realidad Aumentada, el Internet de la Cosas o el Big Data Analytics». Toda organización debería tener el foco puesto en ellas para ver cómo pueden afectar a su negocio.
Células de I+D+i más ágiles
Con esta reflexión da comienzo el artículo que José Miguel Lara, Director de Negocio de F. Iniciativas, escribió en el número de enero-febrero de La Revista APD, tratando de dejar claro que los proyectos de transformación digital, ya sean del sector industrial o de servicios, van a marcar el rumbo de las empresas en los próximos años, y nos van a ayudar a prepararnos para la nueva forma de hacer y entender los negocios con un nuevo perfil de cliente. «El sano ejercicio de explorar y conectarse al ecosistema emprendedor, rodeándose de otras células de I+D+i más ágiles, frescas, especializadas, etc., siempre es una buena forma de descubrir otras soluciones o ideas que pueden cambiar el rumbo de tu negocio», señala.
Las tendencias tecnológicas que más van a mover los pilares de la economía tradicional en el corto plazo son la IA, el Blockchain, la Realidad Aumentada, el IoT o el Big Data Analytics
Para Lara no podemos, además, perder de vista en el plan estratégico de nuestro negocio el impacto que puede tener un cambio de modelo a una mayor implantación de la Economía Circular, donde más pronto que tarde tendremos que gestionar el equilibrio de lo económico con lo ambiental debido al agotamiento de una serie de recursos naturales.
Más inversión en innovación
La Administración Pública pone a nuestro alcance un sistema de incentivos fiscales y financieros con el objetivo de aumentar la inversión en I+D+i del sector privado, y que ayudan a este a acelerar el proceso de inversión y minimizar el tiempo y el riesgo tecnológico. Así, el correcto tratamiento de estos incentivos, según el director de Negocio de F. Iniciativas, «puede suponer un retorno fiscal de entre un 12% y un 59% de los gastos del ejercicio. Además, podemos solicitar fondos públicos que pueden financiarnos hasta un 70% del proyecto».
En definitiva, «apostar por la innovación de forma estable en el tiempo y con determinación, tanto por parte de las empresas como de los gobiernos en cuanto a políticas de incentivación, ha sido, es y será la clave para la competitividad y el crecimiento empresarial, y para la evolución de nuestra sociedad», concluye.